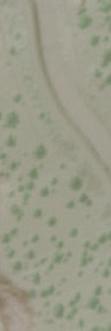

Cash
RealEstateAgentCommissions
Reconveyance/ReleaseFees
PrepaymentPenalties(IfApplicable)
Owner'sTitleInsurance
EscrowFee
TaxProrations
LienSearch(ifapplicable)
Mortgages&Encumbrances
AnyPropertyTaxDue
Buyer'sLenderFees(variesbylender)
AppraisalFee
LoanOriginationFee/Discount CreditFee
MortgageInsurance(ifapplicable)
ReserveSetUpFee(ifapllicable)
FireInsurance1year(homeownerspolicy)
Floodinsurance(ifapplicable)
FloodandTaxCertifications
PrepaidInterest
HomeOwnersAssociationFees(ifapplicable)
VAFundingFee
RecordingFee
TaxProration
EscrowFee
LendersTitleInsurance
* Items listed are intended to represent only what may be customarily charged and may not reflect actual charges at closing. Consult with your real estate professional or title company representtaive for actual charges specific to your transaction.
Seller to pay full escrow fee (includes buyer escrow fee)




This week the median list price for Terrebonne, OR 97760 is $684,900 with the market action index hovering around 37. This is an increase over last month's market action index of 34 Inventory has decreased to 21.
This answers “How’s the Market?” by comparing rate of sales versus inventory.
Home sales continue to outstrip supply and the Market Action Index has been moving higher for several weeks. This is a Seller’s market so watch for upward pricing pressure in the near future if the trend continues
Each segment below represents approximately 25% of the market ordered by price.
Again this week we see prices in this zip code remain roughly at the level they’ve been for several weeks. Since we’re significantly below the top of the market, look for a persistent up-shift in the Market Action Index before we see prices move from these levels.
In the quartile market segments, we see prices in this zip code generally settled at a plateau, although Quartile 1 is on a bit of an up trend in recent weeks. We'll need to see a persistent shift in the Market Action Index before we see prices across the board move from these levels.
The value placed on homes appears to be on the upswing, despite the fact that prices in general have remained basically flat. These conditions can arise when inventory is light and a greater number of smaller homes have more influence on overall prices.
Inventory has been falling in recent weeks. Note that declining inventory alone does not signal a strengthening market. Look to the Market Action Index and Days on Market trends to gauge whether buyer interest is changing with the available supply.
Home sales continue to outstrip supply and the Market Action Index has been moving higher for several weeks. This is a Seller’s market so watch for upward pricing pressure in the near future if the trend continues.
Not surprisingly, all segments in this zip code are showing high levels of demand. Watch the quartiles for changes before the whole market changes. Often one end of the market (e.g. the high-end) will weaken before the rest of the market and signal a slowdown for the whole group.
The properties have been on the market for an average of 155 days. Half of the listings have come newly on the market in the past 121 or so days. Watch the 90-day DOM trend for signals of a changing market.
It is not uncommon for the higher priced homes in an area to take longer to sell than those in the lower quartiles.

AreaProfiled:CrookedRiverRanchPh1
ReportDate: 04/02/2024
SalesDates: 09/01/2005-02/28/2024
NumberofParcels:236
WaterfrontParcels:0
AverageSalePricebyYear:01/01/2016-04/02/2024

*89sale(s)areincludedinthegraph **36sale(s)withnosalepriceareexcludedfromthegraph
SalesStatisticsbyYear:01/01/2016-04/02/2024

ParcelswithViews:0
AverageLengthofResidence
*168parcel(s)areincludedinthecalculation **68parcel(s)withnosaledateareexcluded fromthecalculation


SUBJECTPROPERTY
7951
JeffersonCounty
ADDRESS
6055SWCougarRd
Terrebonne,OR97760
OWNER
White,Shane
White,Melinda
DATE
04/02/2024
PREPAREDBY DanettaRider danettar@deschutestitle.com


To estimate the initial RMV for your property, your county assessor appraises your property using a physical inspection and a comparison of market data from similar properties. For ensuing tax years, your county assessor may study trends of similar properties to update the RMV for your property.
Maximum Assessed Value (MAV) was established by Ballot Measure 50 for the 1997-98 tax year. MAV is the greater of 103% of the prior year's assessed value (AV), or 100 percent of the prior year's MAV, whichever is greater.
MAV’s for properties that existed prior to 1995 were set based on the 1995-1996 Real Market Value (RMV) less 10%. MAVs for “new” properties (constructed or created after 1995) are set by multiplying the property's Real Market Value (RMV) at the time of construction or creation by the Changed Property Ratio (CPR) for that year.
MAV is the only part of your tax bill where a 3% increase limit applies. However, your MAV can increase above 3 percent of the prior year's assessed value if certain things defined as exceptions are made to your property.
Assessed Value (AV) is the lower of last year’s Maximum Assessed Value (MAV) plus 3%, or the current Real Market Value (RMV). This value provides the baseline for your tax bill calculation.
Account 521695 Assessment Summary
Account Value History Reports Files Property Search Online
Manufactured Structure
Situs Address 6055 SW COUGAR RD TERREBONNE, OR 97760
Mailing Address
WHITE, SHANE & MELINDA
PO BOX 911
PROSSER WA 99350-0911 Map and Taxlot
Account Status A
*Subtype R
Stat Class 462
* Account is taxed on Real Property Account 7951
Manufactured Structure
For tax purposes, a manufactured structure is a:
Manufactured dwelling, or Prefabricated structure more than 8½ feet wide that can be moved to a new location, or Recreational vehicle more than 8½ feet wide, constructed for movement on public highways.
It can be used for a residence or for business, commercial, or office purposes. Most manufactured structures are assessed by the county.








ParcelID:7951
TaxAccount#:131235D001700
6055SWCougarRd, TerrebonneOR97760
Thismap/platisbeingfurnishedasanaidinlocatingtheherein describedlandinrelationtoadjoiningstreets,naturalboundariesand otherland,andisnotasurveyofthelanddepictedExcepttotheextent apolicyoftitleinsuranceisexpresslymodifiedbyendorsement,ifany, thecompanydoesnotinsuredimensions,distances,locationof easements,acreageorothermattersshownthereon

Clink the Hyperlink on the next page to view Electronically






 Sw alley Irrigation Dist (DRIC)
Central O rego n Irrigation District
Thre e Siste rs Irrigation District
Sw alley Irrigation Dist (DRIC)
Central O rego n Irrigation District
Thre e Siste rs Irrigation District
Station #402
Station #403

 Redmon d RFP D
Redmon d RFP D
St Charles Medical Cen ter - Red mo nd
Redmon d RFP D
Station #401
Redmon d RFP D
Station #404
Redmon d Police Department
Deschu tes Count y Sh eriff - Terreb onn e
Cro oked River Ran ch
Redmon d RFP D
Redmon d RFP D
St Charles Medical Cen ter - Red mo nd
Redmon d RFP D
Station #401
Redmon d RFP D
Station #404
Redmon d Police Department
Deschu tes Count y Sh eriff - Terreb onn e
Cro oked River Ran ch


Borden Beck Wildlife Preserve
Tetherow Park
Tetherow Crossing
Dry Canyon Trail Quince Park
Hathaway Park
Cline Falls
State Scenic Viewpoint
Smith Rock State Park
Diamond Bar Ranch Park
RAPRD Activity Center
Centennial Park
Baker Park
Hayden Park
Valleyview Park
The Greens Trail Centennial Park Plaza
Redmond-Bend
Juniper State Scenic Corridor

Quartz Park

Glaze M eado w Golf Co urse
Crook ed River Ran ch Golf Co urse
Aspen La kes Golf Co urse
Eag le Crest Resort Cours e
Missin g Lin k Family Golf Cen ter
Eag le Crest Ridg e Cours e Jack Nicklaus Sign ature Cou rse
At Pron gho rn
Pro ng hor n Golf Club
Awbr ey
Glen G olf Cours e
Tethero w Golf Clu b
Widg i Creek Golf Club
Mead ows
Golf Co urse
At Sunr iver
River's Edg e Golf Co urse
Bend Go lf & Coun try Club
Lost Tr acks
Golf Clu b
Woo dland s Golf Co urse
At Sunr iver
Crossw ater Golf Co urse
Quail Run Golf Co urse




ParcelID:7951
TaxAccount#:131235D001700
6055SWCougarRd, TerrebonneOR97760
Thismap/platisbeingfurnishedasanaidinlocatingtheherein describedlandinrelationtoadjoiningstreets,naturalboundariesand otherland,andisnotasurveyofthelanddepictedExcepttotheextent apolicyoftitleinsuranceisexpresslymodifiedbyendorsement,ifany, thecompanydoesnotinsuredimensions,distances,locationof easements,acreageorothermattersshownthereon


ParcelID:7951
TaxAccount#:131235D001700
6055SWCougarRd, TerrebonneOR97760
Thismap/platisbeingfurnishedasanaidinlocatingtheherein describedlandinrelationtoadjoiningstreets,naturalboundariesand otherland,andisnotasurveyofthelanddepictedExcepttotheextent apolicyoftitleinsuranceisexpresslymodifiedbyendorsement,ifany, thecompanydoesnotinsuredimensions,distances,locationof easements,acreageorothermattersshownthereon


ParcelID:7951
TaxAccount#:131235D001700
6055SWCougarRd, TerrebonneOR97760
Thismap/platisbeingfurnishedasanaidinlocatingtheherein describedlandinrelationtoadjoiningstreets,naturalboundariesand otherland,andisnotasurveyofthelanddepictedExcepttotheextent apolicyoftitleinsuranceisexpresslymodifiedbyendorsement,ifany, thecompanydoesnotinsuredimensions,distances,locationof easements,acreageorothermattersshownthereon


ParcelID:7951
TaxAccount#:131235D001700
6055SWCougarRd, TerrebonneOR97760
Thismap/platisbeingfurnishedasanaidinlocatingtheherein describedlandinrelationtoadjoiningstreets,naturalboundariesand otherland,andisnotasurveyofthelanddepictedExcepttotheextent apolicyoftitleinsuranceisexpresslymodifiedbyendorsement,ifany, thecompanydoesnotinsuredimensions,distances,locationof easements,acreageorothermattersshownthereon


ParcelID:7951
TaxAccount#:131235D001700
6055SWCougarRd, TerrebonneOR97760
Thismap/platisbeingfurnishedasanaidinlocatingtheherein describedlandinrelationtoadjoiningstreets,naturalboundariesand otherland,andisnotasurveyofthelanddepictedExcepttotheextent apolicyoftitleinsuranceisexpresslymodifiedbyendorsement,ifany, thecompanydoesnotinsuredimensions,distances,locationof easements,acreageorothermattersshownthereon

Deschutes-Jefferson-Crook County
Tri County Public Services
Administration-Board of Commissioners 541.388.6570
Assessor 541.388.6508
County Clerk’s Recording Office
Community Development 541.388.6575
County Landfill 541.317.3163
Fair & Expo Center 541.548.2711
Fish & Wildlife 541.383.7146
Health Department

541.322.7400
Oregon Highway Information 800.977.6368
Human Resources
541.388.6553
Community Dev/Planning Dept 541.388.6560
Road Department
541.388.6581
Rural Fire District #2 - Non-Emergency 541.318.0459
Sheriff - Non-Emergency 541.693.6911
Surveyor 541.388.6581
Tax Office 541.388.6540
County Clerks Election Office 541.388.6546
Oregon Water Resources Water Master 541.306.6885
Utilities
OR Utility Notification Center-Call Before You Dig 800.332.2344
Cable and Internet
TDS 541.382-5551
Centurylink 855.204.2304
Dish Network
Direct TV/Satellite
Sureline Broadband
Yellow Knife
Electric
Garbage Cascade Disposal
Republic Service (Redmond)
Madras Sanitary
Republic Services (Prineville)
Republic Services
Sun Country Disposal
Wilderness Garbage
Gas
Cascade
CoEnergy
Ferrel Gas
Suburban Propane
Ed Staub & Sons
Telephone AT&T
TDS
BendTel
Cascade Telecommunications
CenturyLink
Neff Networks

-9444
Water Companies
Agate Water 541.382.2855
Avion Water 541.382.5342
Cimarron City Water 541.389.7480
City of Bend Water 541.388.5515
City of Redmond Water 541.923.7765
City of La Pine 541.536.1432
City of Prineville 541.447.5627
City of Madras 541.475.2344
Deschutes Valley Water 541.475.3849
Indian Meadow Water 541.719.0137
Laidlaw Water District 541.389.1255
Long Butte Water 541.383.2863
Roats Water 541.382.3029
Sun Country Water 541.382.5103
Sun Mountain Water 541.382.7309
Sunriver Water LLC 541.593.4197
Terrebonne Water 541.548.2727
Water Wonderland 541.593.2902
Irrigation Districts
Arnold Irrigation 541.382.7664
Central Oregon Irrigation 541.548.6047
North Unit Irrigation 541.475.3625
Ochoco Irrigation 541.447.6449
Three Sisters Irrigation 541.549.8815
Swalley Irrigation 541.388.0658
Tumalo Irrigation 541.382.3053
Recreation & Entertainment
Bend Parks and Rec 541.389.7275
Redmond Area Parks & Rec 541.548.7275
Cascades Theatrical Company 541.389.0803
Deschutes Historical Museum 541.389.1813
Deschutes National Forest Information 541.383.5300
TicketsWest (Ticket Sales) 800.992.8499
High Desert Museum 541.382.4754
Hoodoo Ski Area 541.822.3799
Mt. Bachelor Information 800.829.2442
Mt. Bachelor Ski Report 541.382.7888
Old Mill 16 Cinemas 541.382.6347
Redmond Cinemas 541.548.8777
Tumalo State Park 541.382.3586
La Pine State Park 541.536.2428
Smith Rock State Park 541.516.0054
Newberry Monument Visitor Center 541.383.5300
Police/Sheriff/Fire/Ambulance 911 Report a crime or incident (non emergency) 541.693.6911
Bend Memorial Clinic 541.382.2811
Poison Control Center 800.222.1222
-5551
St. Charles Hospital Bend 541.382.4321
St. Charles Hospital-Redmond 541.548.8131
St. Charles Medical Center –Madras 541.475.3882
St .Charles Hospital Prineville 541.447.6263


Bend

Bend Public Services
Bend Airport
Bend Parks & Recreation
541.388.0019
541.389.7275
Building/Planning/Community Dept 541.388.5580
The Bulletin Newspaper
The Source Weekly
Cascade Business News
City Administration
Chamber of Commerce
Community Development
Dept. of Motor Vehicles
541.382.1811
541.383-0800
541.388.5665
541.388.5505
541.382.3221
541.388.5528
541.388.6322
Deschutes Public Library (Downtown) 541.617.7050
Deschutes Public Library (East Bend) 541.330.3760
Dial-A-Ride (Public Transportation) 541.385-8680
Fire Dept. Non-Emergency 541.322.6300
Humane Society
Juniper Aquatic Center
541.382.3537
541.389.7665
Library Main 541.617.7050
Municipal Court
541.388.5572
Planning Department 541.388.5580
Police Dept. - Non-Emergency 541.693.6911
Bend Schools
Bend / La Pine Information
Transportation
Elementary Schools
Amity Creek
Bear Creek
Buckingham
Elk Meadow
Ensworth
High Lakes
Highland At Kenwood
Juniper
Lava Ridge 541.355.2400
North Star 541.355.2300
Pine Ridge
Ponderosa
R. E. Jewell
Seven Peaks
Silver Rail
Westside Village At Kingston 541.355.2000
William E. Miller
Middle Schools
Cascade 541.355.7000
High Desert 541.355.7200
Pacific Crest 541.355.7800
Pilot Butte 541.355.7400
Realms 541.355.4900
Sky View 541.355.7600
High Schools
Bend Senior High 541.355.3700
Caldera High 541.355-5000
Marshall High 541.355.3510
Mountain View High 541.355.4400
Realms High 541.355.5500
Skyline High 541-355-1000
Summit High 541.322.3300
Redmond
Redmond Public Services
Airport Offices 541.504.3495
Redmond Taxi 541.548.1182
Cascade Swim Center 541.548.6066
Chamber of Commerce 541.923.5191
City Information 541.923.7710
State of Oregon E-Permitting 541.923.7721
Dept. of Motor Vehicles 541.548.0140
Fire Dept. Non-Emergency 541.504.5000
Humane Society 541.923.0882
Police Dept. Non-Emergency 541.388.0170
Post Office 800.275.8777
Redmond Library 541.312.1050
Redmond Airport (Roberts Field) 541.504.3495
Redmond Spokesman Newspaper 541.548.2184
Senior Center 541.548.6325
Redmond Schools
Redmond School District/Transportation 541.923.5437
Elementary Schools
StepUP at Edwin Brown Education Center 541.923.4868
Hugh Hartman 541.923.8900
John Tuck 541.923.4884
M.A. Lynch 541.923.4876
Sage 541.316.2830
Terrebonne Community School 541.923.4856
Tom McCall 541.526.6400
Tumalo 541.382.2853
Vern Patrick 541.923.4830
Middle Schools
Elton Gregory 541.526.6440
Obsidian 541.923.4900
Redmond Proficiency Academy 541.526.0882
High Schools
Redmond High 541.923.4800
Redmond Proficiency Academy 541.526.0882
Ridgeview High 541.504.3600
Sisters
Sisters Public Services
Business Office 541.549.6022
Chamber of Commerce 541.549.0251
Sheriff’s Office Substation 541.549.2302
Post Office 800.275.8777
Police Dept. Non-Emergency 541.692.6911
Sisters Library 541.312.1070
Sisters Schools
Sisters Elementary 541.549.8981
Sisters Middle 541.549.2099
Sisters High 541.549.4045
Sunriver and La Pine
Sunriver Public Services
Chamber of Commerce 541.593.8149
Fire Dept. Non-Emergency 541.593.8622
Police Dept. Non-Emergency 541.593.1014
Sunriver Library 541.312.1080
Sunriver Nature Center 541.593.4394
Sunriver Owner’s Association 541.593.2411
Sunriver Homeowner’s Aquatic & Rec Center 541.585.5000
Sunriver and La Pine (con’t)
La Pine Public Services
Chamber of Commerce 541.536.9771
Fire Dept. Non-Emergency (Admin/Bus) 541.536.2935
Sheriff - La Pine Station Non Emergency 541.693.6911
La Pine Library 541.312.1090
La Pine and Sunriver Schools
La Pine Elementary 541.355.8000
Rosland Elementary 541.355.8100
Three Rivers Element. & Middle School 541.355.3000
La Pine Middle School 541.355.8200
La Pine High School 541.355.8400
Madras
Culver– Madras Public Services
Chamber of Commerce 541.475.2350
City of Culver 541.546.6494
Fire Dept Non-Emergency 541.475.7274
Humane Society 541.475.6889
Jefferson County Assessors Office 541.388.6508
Jefferson County Clerks Office 541.475.4451
Jefferson County Planning Dept 541.475.4462
Jefferson County Landfill 541.475.1983
Madras Aquatic Center 541.475.4253
Madras City Hall & Police Station 541.475.2344
Madras Library 541.475.3351
Post Office 800.275.8777
Elementary Schools
Metolius Elementary 541.546.3104
Madras Primary Elementary 541.475.3520
Madras Elementary 541.475.3520
Middle School
Jefferson County Middle School 541.475.7253
High School
Madras High 541.475.7265
Prineville
Prineville Public Services
Chamber of Commerce 541.447.6304
City of Prineville 541.447.5627
Fire Dept. Non-Emergency 541.447.5011
Humane Society 541.447.7178
Crook County Assessors Office 541.447.4133
Crook County Clerks Office 541.447.6553
Crook County Building/Planning Dept. 541.447.3211
Crook County Park & Recreation Dept. 541.447.7546
Crook County Landfill 541.447.2398
Post Office 800.275.8777
Prineville Library 541.447.7978
Sheriffs Office non-emergency 541.447.6398
Elementary Schools
Barnes Butte Elementary 541.416.4150
Brothers Elementary 541.903.2819
Crooked River Elementary 541.447.6488
Steins Pillar Elementary 541.416.4230
Powell Butte Community Charter 541.548.1166
Middle Schools
Crook County Middle School 541.447.6283
High Schools
Crook County High 541.416.6900
Pioneer Secondary Alter High 541.447.1268


SubjectParcel
SiteAddress 6055SWCougarRd TerrebonneOR97760
Parcel 7951
SchoolDistrict 2JRedmond
AssignedPrimarySchool TerrebonneCommunitySchool
AssignedMiddleSchool TerrebonneCommunitySchool
AssignedHighSchool RedmondHighSchool
PrimarySchool
TerrebonneCommunity School
SchoolMap
MiddleSchool
HighSchool
RedmondHighSchool
OtherSchool

School#1
SchoolDistrict RedmondSD2J
DistFromSubject914miles
School RedmondHighSchool SiteAddress 675SWRimrockDr
City Redmond Zip 97756
Type 1-Regularschool Students 936 Charter No
School#2
SchoolDistrict RedmondSD2J
DistFromSubject464miles
School TerrebonneCommunitySchool SiteAddress 1199BAve
Terrebonne Zip 97760


American
297
PRINCIPAL: Cyndi Ganfield | GRADES: K-5 | 1199 B Ave, Terrebonne 97760 | 541-923-4856
School Environment
Students who attended more than 90% of their enrolled school days.
20.5
2021-22

Academic Progress
Year-to-year progress in English language arts and mathematics.
Data not available in 2021-22
64% Oregon average
Students meeting state grade-level expectations. 47%
Students meeting state grade-level expectations.
Students meeting state grade-level expectations.
43%

This year, we will be focusing on:
· Reengaging families and community in a post-COVID world
· A robust PBIS system that encourages safe and positive behaviors to promote caring and connecting
· Increasing reading and math achievement by bridging learning gaps for all students
The Oregon Department of Education is partnering with school districts and local communities to ensure a 90% ontime, four year graduation rate by 2025. To progress toward this goal, the state will prioritize efforts to improve attendance, provide a well-rounded education, invest in implementing culturally responsive practices, and promote continuous improvement to close opportunity and achievement gaps for historically and currently underserved students.
It is our priority that all RSD students and families feel safe, welcome and included. Our students are entitled to academic success regardless of background or family circumstances, and each student will be provided the necessary support to ensure success. We are committed to sustaining an inclusive and culturally responsive school culture/climate for all students, families and staff. We ensure safe schools through prevention, intervention, behavioral-emotional health and crisis preparedness.

Our Staff (rounded FTE)






17 Teachers
American Indian/Alaska Native <10 students or data unavailable
Asian
Black/African
6 Educational assistants
2 Counselors/ Psychologists
86%
83%
RSD considers the safety of children our greatest priority. Everyone is welcome in school and we recognize the diversity and worth of all. We ensure physically and psychologically safe, secure and orderly learning environments. Elementary schools use the Positive Behavior-Intervention Support system to provide proactive instruction and student need-based tiered supports. Full-time counselors provide whole and small group and individual support for bullying prevention. RSD uses SafeOregon to report unsafe behavior and follows all policies outlined in our Rights & Responsibilities Handbook.
students or data unavailable
<10 students or data unavailable
<10 students or data unavailable

<10 students or data unavailable
<10 students or data unavailable
<10 students or data unavailable
<10 students or data unavailable
<10 students or data unavailable
<10 students or data unavailable
<10 students or data unavailable
<10 students or data unavailable
<10 students or data unavailable
<10 students or data unavailable
<10 students or data unavailable
<10 students or data unavailable
<10 students or data unavailable
· Community youth sports programs
· Champions (before and after school program)
· After school Enrichment Programs
· Back to School Night/Open House
· Parent Volunteer Opportunities
· Family make and take night
· Family STEAM night
· Title 1 Family night
· Parent Teacher Club
· Monthly Awards Assemblies
· Volunteer opportunities
· SMART Reading program
· Outdoor School Volunteers
· Guest Speakers
· Family and Community nights


PRINCIPAL: Audrey Haugan | GRADES: 9-12 | 675 SW Rimrock Dr, Redmond 97756 | 541-923-4800
School Environment
Median size of classes in core subjects.
Students who attended more than 90% of their enrolled school days.
50%
Students earning a diploma within four years. Cohort includes students who were first-time ninth graders in 2017-18 graduating in 2020-21
Students earning a high school diploma or GED within five years. Cohort Includes students who were firsttime ninth graders in 2016-17 finishing in 2020-21
80%
88% Oregon average 88%

For 2022-2023, Redmond High School will:
- Increase our overall four-year graduation rate to 85%
- Increase our four year graduation rate of students in Special Education by 8% (to 72%)
- Implement the AVID College Readiness System with school-wide and targeted programming
- Increase the number of Freshmen who are on track to graduate at the end of their 9th grade year to 95%
The Oregon Department of Education is partnering with school districts and local communities to ensure a 90% ontime, four year graduation rate by 2025. To progress toward this goal, the state will prioritize efforts to improve attendance, provide a well-rounded education, invest in implementing culturally responsive practices, and promote continuous improvement to close opportunity and achievement gaps for historically and currently underserved students.
2021-22

Students earning one-quarter of graduation credits in their 9th grade year.
82%
Students enrolling in a two or four year college within 16 months of completing high school in 201920. Data from the National Student Clearinghouse.
37% Oregon average 56%
It is our priority that all RSD students and families feel safe, welcome and included. Our students are entitled to academic success regardless of background or family circumstances, and each student will be provided the necessary support to ensure success. We are committed to sustaining an inclusive and culturally responsive school culture/climate for all students, families and staff. We ensure safe schools through prevention, intervention, behavioral-emotional health and crisis preparedness.

Our Staff (rounded FTE)






American Indian/Alaska Native <10 students or data unavailable
44 Teachers
6
Asian <10 students or data unavailable
<10 students or data unavailable
<10 students or data unavailable
<10 students or data unavailable

<10 students or data unavailable
<10 students or data unavailable
<10 students or data unavailable
5
87%
85%
Redmond High School offers a range of rigorous and college credit-earning coursework, including:
- College Now courses in CTE, Math, English, and History
- Advanced Placement Statistics, Calculus, Spanish, Biology, US History, Studio Art, Language and Composition, Literature and Composition, Chemistry, and Human Geography
- Expanded Options Program provides access to on campus college courses for students who qualify
- AVID Elective curriculum provides rigorous preparation for students to realize success in college level coursework grades 9-12.
Redmond High School is proud of its robust CTE programs of study. We offer industryready training in the following Career Pathways:
- Automotive Technology
- Agriculture Science
- Business and Entrepreneurship
- Construction Technology
- Manufacturing and Engineering
- Computer Science
Redmond High School’s CTE instructors are industry experts, with strong connections to employers and higher education providers in the trades. Students in Career Pathways participate in internship and practicum placements with local employers, and have access to the latest in technology and equipment.
We offer an array of Co- and Extracurricular opportunities:
Athletics
- Fall - Cheerleading, Cross Country, Football, Soccer, Volleyball
- Winter - Cheerleading, Basketball, Swimming, Wrestling
- Spring - Baseball, Golf, Softball, Tennis, Track
We offer a range of co-curricular opportunities building confidence, character and connection to our school community. These include:
- Student Leadership
- Student Government
- Speech & Debate
- National Honor Society
- Thespian Club
- Skills USA
- JROTC
- Guitar Club
- Yearbook
- Future Farmers of America
- Choir
- Band
Our school partners with parents by hosting a variety of events and engagement opportunities including an open house, parent conferences, concerts, performances and athletic events.
Our school also values partnerships with local businesses and community organizations to improve opportunities for our students.
See our school website for a calendar of parent engagement events.

































Crooked River Ranch was developed by Bill Macpherson in 1972 as a destination resort. In 1973 on November 15th the first meeting of the Crooked River Ranch Club & Maintenance Association (CRR) was established, and a year later the new clubhouse and pool with the first 9 holes of the golf course were built. In 1980 CRR was re-zoned from recreational to rural/residential. In 1992 final re-zoning took place, making CRR a residential subdivision. The properties are divided into 1, 2, and 5 acre lots. The Ranch itself is divided into 16 phases. There are also numerious commercial properties/businesses near Admin. building and on Commercial Loop. Crooked River Ranch Club & Maintenance Association is a nonprofit corporation consisting of 2,646 properties.
It is now the largest homeowner's association in Oregon, having grown to over 5000 in population. It is considered as becoming the largest subdivision of its kind. It employs over 25 people and utilizes many volunteers to keep our owners and guests satified during their stay on the Ranch.
As with all Home Owners Associations, dues are collected to assist in maintaining the common properties, which the association owns. Dues are collected bi-annually. With dues comes use of the pool, tennis, and discounts on golf (18 hole course), ball field, arena and other amenities.
The nine member association Board of Directors meets monthly, which all home owners are welcome to attend. There is also an annual meeting usually around Labor day.
Crooked River Ranch Club & Maintenance Association has developed its Articles of Incorporation and Bylaws. Each phase has it s own Covenants, Conditions & Restrictions.

PO Box 1502
Crooked River Ranch, OR 97760
541-923-2679
info@crrchamber.com
The Crooked River Ranch Golf Course offers 18 well maintained holes in a magnificent river canyon setting. The fifth hole has been cited as the most spectacular hole in Central Oregon. The golf course is open for play almost all year, except for a few short lived winter snowfalls. You'll be pleased at how affordable this beautiful golf course is. It is also open to the general public.
You and your family will enjoy fishing and boating in the scenic Crooked and Deschutes Rivers. The "Ranch" is also just a short drive from Lake Billy Chinook and Haystack Reservoir which provide a boating, fishing and fabulous scenery.
When you visit the "Ranch", you will enjoy several events and festivals, including the "Steel Stampede" Vintage Motorcycle Rally in late April/early May, the Senior's popular community yard sale late May/early June, the "Independence Celebration" which includes a Parade, "Buffalo Feed", a Quilt Festival and Craft Fair in July, "Olde Fashioned Christmas" which includes a Holiday Bazaar, Santa visits and photos and a "Starlight Parade" in December, and more. Check the web site for updated information and exact dates.
Camping, hiking and picnicking are close by. You'll love hiking the scenic trails throughout the area, and will enjoy the BLM land which adjoins the Ranch. Don't miss the scenic hike to Steelhead Falls. Beautiful MacPherson Park is located near the golf course, and provides a covered pavilion, spacious lawns and a pond where ducks, bullfrogs, Muflong sheep, a variety of birds and the ever popular deer offer ongoing entertainment to children and adults alike. Wildlife is always present for you to enjoy at Crooked River Ranch.
For the enjoyment of residents and visitors, the Ranch maintains a heated swimming pool, which includes a large "kiddy pool". The pool is open from Memorial Day to Labor Day, and later, if the weather permits.
Crooked River Ranch is truly an affordable and convenient Destination Resort! You and your family will enjoy the lighted tennis courts, basketball courts, ball field, motel, restaurants, indoor and outdoor meeting and small conference facilities, mini market, a full service beauty salon. Catering can also be arranged. Not only is the Ranch an exciting place for a family vacation, it is also a wonderful place for a year ‘round retreat for your small to mid size business, church group and family and high school reunions.
The Ranch owns and operates a full service RV Park, complete with full hook ups, a covered pavilion, showers, washers and dryers and a children's playground. 50amp service is available at select sites. There are other privately owned RV Parks for your camping enjoyment.
The Ranch Chapel is a nondenominational house of worship which offers two Sunday morning services, Sunday School, youth programs and Bible study. Everyone is welcome. Visit our website http://ranchchapel.org/
If you love a challenge, rock climbing may be for you. The internationally acclaimed Smith Rock is just a short drive from the Ranch, and offers the rock climbing experience, together with hiking for young and old alike along some of the most scenic trails you'll ever have the opportunity to enjoy. Visit: http://www.smithrock.com/ or http://www.oregonstateparks.org/park_51.php for more information.
"Ranchers" take care to preserve the quality of life that attracts visitors to enjoy scenic vistas and quiet beauty, away from the hustle and bustle of the big cities. We welcome new residents and visitors alike who, we are sure will agree that the Ranch is a "great place to hang your hat."

https://www.visitbend.com/food-drink/restaurants/food-carts/
https://www.google.com/search?q=food+carts+near+me&rlz=1C1GCEU_enUS874US875&oq=food+ca rts+&aqs=chrome.2.69i57j0i512j0i457i512j0i402j46i175i199i512l2j0i512l4.9132j0j15&sourceid=chrom e&ie=UTF-8
https://www.menupix.com/oregon/cn/158/370037/Food-Trucks-Prineville
https://www.google.com/search?q=food+trucks+in+sisters+oregon&rlz=1C1GCEU_enUS874US875&ei =nMxVYpS4Ns2dkPIPufeDoAg&oq=food+trucks+in+Sisters&gs_lcp=Cgdnd3Mtd2l6EAEYADIFCAAQgAQ yBQgAEIYDMgUIABCGAzoLCC4QgAQQxwEQrwE6BggAEBYQHkoECEEYAEoECEYYAFAAWPcKYNAiaABw AXgAgAHRAYgBugmSAQUwLjYuMZgBAKABAcABAQ&sclient=gws-wiz
https://www.google.com/search?q=food+trucks+in+madras&rlz=1C1GCEU_enUS874US875&ei=nMxV YpS4Ns2dkPIPufeDoAg&ved=0ahUKEwiU9pOLm4_3AhXNDkQIHbn7AIQQ4dUDCA8&uact=5&oq=food +trucks+in+madras&gs_lcp=Cgdnd3Mtd2l6EAMyBggAEBYQHjIFCAAQhgMyBQgAEIYDOgcIABBHELADO goIABBHELADEMkDOggIABCABBDJAzoFCAAQkgM6BQgAEIAEOgsILhCABBDHARCvAUoECEEYAEoECEYY AFDeEliMGmDVHGgBcAF4AIABrQGIAZoHkgEDMC42mAEAoAEByAEHwAEB&sclient=gws-wiz
https://www.google.com/search?q=food+trucks+in+culver+oregon&rlz=1C1GCEU_enUS874US875&ei =bM1VYqjDC_bTkPIP_Zuj2AY&ved=0ahUKEwioqYDum4_3AhX2KUQIHf3NCGsQ4dUDCA8&uact=5&oq =food+trucks+in+culver+oregon&gs_lcp=Cgdnd3Mtd2l6EAMyBQghEKsCOgoIABBHELADEMkDOgcIABB HELADOgYIABAWEB46BQgAEIYDOgUIIRCgAUoECEEYAEoECEYYAFD2BljNDmCFEGgBcAF4AIABswGIAcQ JkgEDMC43mAEAoAEByAEEwAEB&sclient=gws-wiz
https://pdx.eater.com/maps/best-restaurants-bend-oregon-guide
https://www.visitbend.com/food-drink/restaurants/vegan-vegetarian-gluten-free/
https://www.google.com/search?q=healthy+eats+in+central+oregon&rlz=1C1GCEU_enUS874US875& ei=Vs5VYo6xJp_TkPIPjIqV4AI&ved=0ahUKEwiOtOXdnI_3AhWfKUQIHQxFBSwQ4dUDCA8&uact=5&oq =healthy+eats+in+central+oregon&gs_lcp=Cgdnd3Mtd2l6EAM6BggAEAcQHjoICAAQBxAFEB46BQgAEI YDSgQIQRgASgQIRhgAUABYjyhg6D5oAnABeAGAAe8DiAHND5IBCjIuMTAuMS4wLjGYAQCgAQHAAQE &sclient=gws-wiz
https://forgetsomeday.com/things-to-do-in-bend-oregon-with-kids/
https://www.cascadiakids.com/things-do-kids-bend-oregon/
https://oldmilldistrict.com/things-to-do-with-kids/
https://www.visitbend.com/things-to-do/activities/kid-family-friendly-activities/
https://visitcentraloregon.com/dining/food/farmers-market/
https://www.localharvest.org/prineville-or/farmers-markets
https://hdffa.org/its-farmers-market-season/
https://redmondoregonfarmersmarket.com/
https://www.sistersfarmersmarket.com/
https://www.localharvest.org/redmond-or/farmers-markets
https://www.madrassaturdaymarket.com/
https://www.visitbend.com/food-drink/restaurants/brewery-pub/
https://www.google.com/search?q=breweries+in+central+oregon&rlz=1C1GCEU_enUS874US875&oq =&aqs=chrome.0.69i59i450l8.68566434j0j15&sourceid=chrome&ie=UTF-8
https://visitcentraloregon.com/dining/drinks/breweries/redmond/
https://beermebend.com/bend-oregon-brewery-locations/
https://www.google.com/search?q=prineville+breweries&rlz=1C1CHBD_enUS1025US1025&oq=prine ville+breweries&aqs=chrome..69i57j0i22i30j0i390i650.4688j0j7&sourceid=chrome&ie=UTF-8
https://www.google.com/search?q=breweries+in+madras+oregon&rlz=1C1CHBD_enUS1025US1025& oq=breweries+in+madras+oregon&aqs=chrome..69i57.6398j0j4&sourceid=chrome&ie=UTF-8
https://www.niche.com/k12/search/best-private-schools/c/deschutes-county-or/
https://movingtobend.com/relocation-blog/2021/a-guide-to-public-and-private-schools-in-bendoregon/
https://www.countyoffice.org/bend-or-private-schools/
https://www.visitbend.com/things-to-do/activities/winter-fun/
https://visitcentraloregon.com/things-to-do/activities/winter/
https://www.google.com/search?q=winter+activities+central+oregon&rlz=1C1CHBD_enUS1025US102 5&oq=winter+activities+central+oregon&aqs=chrome..69i57j0i22i30l2j0i390i650l3j69i60l2.14288j0j4 &sourceid=chrome&ie=UTF-8
https://www.riversplacebend.com/games
https://beermebend.com/bend-oregon-brewery-locations/
https://www.bendsource.com/bend/bingo-with-bren-supporting-saving-grace/Event?oid=16320982
https://www.visitbend.com/food-drink/astro-lounge/
https://theyardfoodpark.com/events/
https://www.silvermoonbrewing.com/events
https://www.bendsource.com/bend/tuesday-night-trivia-in-redmond/Event?oid=18829261
https://visitcentraloregon.com/calendar-of-events
https://www.bendsource.com/bend/EventSearch?v=g#grid
https://www.visitbend.com/event-calendar/









Where the commute times are short and breathtaking views await you at every turn. The region features dramatic snow-capped mountain ranges and high desert plateaus within Deschutes, Crook and Jefferson counties.
Located halfway between San Francisco and Seattle, one of the hottest small metropolitan markets in the U.S. is Central Oregon. In the last decade the region has seen some of the highest sustained GDP growth, job growth and population growth. With these factors in mind, The Milken Institute has named the region the best small metropolitan in the nation four years in a row – an unprecedented feat no other location has ever received.
Central Oregon is pulling extraordinary talent and capital, fostering a diverse and highly entrepreneurial business ecosystem. Deschutes County received the most investment in Oregon in 2022, according to Smartasset. Lured by natural scenic beauty and big city amenities without big city costs or hassle, people are learning that having a true work-life balance is possible. Employees are happier and companies are more innovative and capital-efficient. All in a region dominated by small to mid-sized firms that compete globally – and win.
Regional Population:
(2021 estimates from Portland State University)
Regional Labor Force:
(Seasonally adjusted total for 2021 from Oregon Employment Department)
253,761
123,953
Bend-Redmond MSA GDP Per Capita: $54,390
(2020 estimate from the Bureau of Economic Analysis) *Bureau of Economic Analysis data is only available for the Bend-Redmond MSA

Access to and from our region has never been easier with five national carriers flying up to 54 segments daily to nine international airports. Central Oregon is served by one of the most vibrant and successful regional airports in the country at Redmond (RDM).

Central Oregon has been among the fastest growing regions anywhere in the U.S.
In-migration has been the dominating factor in the region’s growth. With millions of visitors annually, Central Oregon continues to attract thousands of new residents from all over the country each year for it’s outdoor amenities, arts and culture opportunities, quality healthcare, and a growing education system.
“Central Oregon’s economic growth is stronger than the state and nation overall. The primary reason is the high quality of life that attracts new residents. Faster population growth means local businesses
can
hire and expand at a faster rate due to the influx of working-age migrants and the growing labor force.”
Josh Lehner Economist, Oregon Office of Economic Analysis
With over 4.5 million visitors flocking to Central Oregon each year, it proves a great introduction to our region’s culture, lifestyle and a great first impression for businesses. Central Oregon and the Bend-Redmond MSA continually top the nation in population growth. In fact, Bend has been among the 15 fastest growing cities in the U.S. five of the last six years. While our population grows, so does our workforce. We’re cultivating a community that has consciously decided to live here and attracting new talent pools to serve the increasing demand for labor.
Oregon offers more incentive programs to traded-sector* businesses than Washington or California. Even without taking those incentives into consideration, Oregon is still a more cost-effective choice for doing business. Contact EDCO for a detailed look at the business costs in Central Oregon. *companies that sell their products
We guide employers outside the region through the relocation process as a resource for regional data, incentives, talent, site selection, and A-Z problem solving.




Sources: Tax Foundation 2022, US Energy Information Association (Natural Gas) 2021, US Energy Information Association (Electricity) 2021

“While our move to Central Oregon may have started for personal reasons, it has allowed us to do more with our business than we thought possible. It has allowed us to hire amazing employees – the available talent here in Central Oregon has proven to be of the highest caliber and chocked full of integrity. Sometimes you feel like you can get lost in a big city. In Sisters we have been able to be part of a growing and nurturing business community.” - Wyatt Woods, President and Owner, Holy Kakow

Founded in Portland in 2009, Holy Kakow creates premium organic chocolate sauces and syrups that are used in coffee shops across the nation and globe. After running the business for nearly a decade, Founder Wyatt Woods decided a move to the City of Sisters would be beneficial for his family. The next step was to figure out how to move the successful business. After EDCO’s help with site selection, incentives, permitting, and more, Holy Kakow was able to move their operations into a new building in the Sisters Business Park. The relocation allowed them to scale for growth, even during the pandemic, expanding their employment from three to eight in the span of a couple months. Holy Kakow have their sights set on new product launches. With the backing of the community and the growing number of craft food businesses in Sisters, the company is surrounded by a strong business ecosystem to help them succeed.
Get connected to our growing industry clusters that include: craft brewing/distilling, bioscience, outdoor products, technology, aerospace, and advanced manufacturing.
We link you to tools to help your company including: connections to the local supply chain, talent acquisition, incentives, business finance, market intelligence, and more.
Central Oregon offers a pro-business environment with several incentives and supportive business finance options to encourage economic growth. Oregon also allows corporate net operating losses to be carried forward for up to 15 years without a cap, which can meaningfully reduce your business’s tax liability.
We help you navigate the regional and local real estate market, infrastructure and permitting processes.

For businesses looking to relocate, Central Oregon has a reputation for welcoming new companies. The region offers a tightknit community without sacrificing talent, education opportunities, or quality healthcare. EDCO’s network can help your business streamline decisions when choosing a new home.
We mentor and advise scalable young companies from concept to exit on issues such as access to capital, critical expertise and business strategy.

“The support we’ve received from EDCO and other organizations has been tremendous and allowed us to grow and develop our network and further develop our business in a short time. Their proactive approach to assisting and encouraging entrepreneurship in this region has been paramount to some of the large strides we’ve taken this year.”
- Ryan Goodwin, Founder & Lead Designer Engineer, SherpTekSherpTek was among the first tenants to take occupancy in the redeveloped Woodgrain mill site, re-branded the “Prineville Campus,” where they design and manufacture modular truck bed systems and accessories to improve the functionality and adaptability of pickup trucks for day-to-day use and outdoor adventures.

SherpTek is an innovator in the automotive/outdoor industry. Their Founder and Lead Design Engineer, Ryan Goodwin, uses composite aerospace materials and construction methods to create a lightweight, yet super durable, precision-engineered product. SherpTek was one of Prineville’s first companies to pitch at EDCO’s Central Oregon PubTalk, an event that showcases local entrpreneurs. The company has been and continues to be supported by EDCO as well as many local and State partners in areas such as business financing, incentive utilization, internship coordination, staffing, network connections, scalability, and pitch coaching. Despite having just moved their start-up to Prineville earlier this year, SherpTek has ingrained itself into the entrepreneurial fabric of the region. They are already expanding their manufacturing facilities, hiring additional employees and training local high school students on their specialized processes.

A driving force for our economic performance is a collaborative and inclusive entrepreneurial community. This is supported via the number of new business registrations, which has outpaced far larger cities. In 2022, AdvisorSmith ranked Bend fifth for Top Midsize Cities where Americans Start the Most Businesses at 3.79 businesses started per 1,000 residents.
The region is large enough to provide resources and access to capital that help new entrepreneurs get started, while still being small enough that those resources are interconnected to support businesses as they grow. Unique to Central Oregon, given its size, are the numerous community resources and assets that are available. Assets managed by EDCO include monthly Central Oregon PubTalks, the Stable of Experts mentorship program and the largest Angel Conference in the PNW, the Bend Venture Conference.

Both Redmond and Bend made WalletHub’s Top 30 list for best cities to start a business at #16 and #17 respectively, based on an index of criteria that included business environment, access to resources and business costs. They were the only two Oregon cities to make it in the top 350 of 1,334 small cities ranked in the index.
We partner with local traded-sector companies to help them grow and expand, offering them the very same incentives and assistance as relocation projects.

“Our flagship manufacturing facility is located in Bend, nestled at the base of the Cascade Mountain Range, which also inspired the brand name. The views and outdoor amenities are unmatched, but the entrepreneurial and community support we have received from day one has been the driving factor in bringing our homegrown business sustainable success in Oregon and beyond. Our employees, customers and partners are what make Bend home and inspire continued growth.”
- Affton Coffelt, Founder and CEO, Broken Top Brands
Broken Top Brands creates handmade, sustainable, eco-conscious candles and body products that have been featured in National media outlets such as BuzzFeed, Oprah Daily and HuffPost. Started in 2015 out of Founder Affton Coffelt’s kitchen in Bend as Broken Top Candle Co., the company has now blossomed to 19 employees and recently moved into an 18,000 SF manufacturing facility.
Broken Top Brands is currently selling an array of all natural, biodegadble and paraben-free lifestyle products in the USA, as well as Canada and parts of Europe. The brand’s market is primarily wholesale with an organically growing e-commerce presence. Customers can find their products in over 2,800 retail locations nationally and internationally, with Whole Foods being their largest account.
Broken Top Brands was attracted to starting a business in Central Oregon for its quality of life and supportive community. Due to it’s unique company culture and location, the business has had success retaining employees which has enabled its continued expansion. Although supply chain timelines and transportation costs have been challenges through the pandemic, Broken Top Brands has sustained steady growth and continues to partner with EDCO, 1% for the Planet, One Tree Planted, Opportunity Knocks, Bend Chamber, and Business Oregon to serve their loyal customer base.
Private sector employment grew by 47% in Central Oregon over the last 10 years, which is significantly faster than the statewide growth of around 20%. Employment in the private sector is projected to grow by 12% across the region between 2019 and 2029.
-Now in its fourth year, Youth CareerConnect (YCC) continues to connect employers and students with real work experience throughout Central Oregon. By supporting internships and experiential learning opportunities in the community, YCC has made it simpler for schools and employers to connect while fostering a work-ready labor force for years to come.
Damon Runberg, Oregon Employment Department


YCC Internship Coordinators host office hours at schools across the region to help students with professional goal setting, resume writing, interview skills, and internship placement for high school, college and alternative education students. Since its inception in 2017, YCC has built a rolodex of over 360 business partners and placed more than 493 students in meaningful internships. Personalization for both the business and the student is at the core of what YCC does, and why it continues to thrive. To get involved with Youth CareerConnect, visit: youthcareerconnect.org
“Central Oregon enjoys a truly collaborative environment. Everyone is not only supportive of each other, but excited to see one another grow. We share the same trails, rivers and slopes and ultimately share a similar vision to help the region succeed.”
- Scott Allan , Former CEO and GM, Hydro Flask
The combination of a collaborative culture, a supportive attitude among government and economic development partners, plus a location that attracts talent and investment all help Central Oregon compete nationally.

Redmond Municipal Airport (RDM; www.flyrdm.com ) provides commercial air service with an average of 27 daily outbound flights to Burbank, Denver, Los Angeles, Palm Springs, Phoenix, Salt Lake City, San Diego, San Francisco, and Seattle via five carriers (Alaska, American, Avelo, Delta, and United).

Burlington Northern-Santa Fe (BNSF), Union Pacific (UPRR) and the City of Prineville Railway (COPR) provide direct connections for shipping to any market in the United States, Canada and Mexico.

U.S. Highways 97 and 20 are two of the State’s major trucking routes, with access to major metro areas with connections to Interstate 5 (N-S) and Interstate 84 (E-W).
The Central Oregon average commute time is 24 minutes each way, saving the average worker nearly one work week per year !
Source: Census.gov 2021

Most of our region has been newly built in the past two decades, making Central Oregon’s telecommunications infrastructure one of the Northwest’s most technologically advanced. Businesses and telecommuters benefit from reliable fast data speeds and upload times.

Central Oregon is well-recognized for its high level of education, with some of the best K-12 public schools in the nation. In 2021, the Bend-La Pine school district’s average SAT scores surpassed the national average by over 180 points. Additionally, our higher education opportunities abound. From Oregon State University-Cascades’ ongoing expansion, to Central Oregon Community College’s four campuses in the region, there are opportunities for all to obtain a quality education.

St. Charles Health System is the largest healthcare provider in the region, and is also the largest employer with over 4,500 employees across the tri-county area. The hospital received HealthGrade’s 2021 Pulmonary Care Excellence Award™ and offers a network of more than 100 clinics and specialty practices throughout the community.

According to the Oregon Employment Department, 76% of Oregon establishments have between one and nine covered payroll employees and the average private establishment employs around 11 people. Still, a number of large employers operate successfully here, tapping into Central Oregon’s ever-expanding workforce, the overall low cost of doing business and business-friendly local governments. This year, the top 50 private companies collectively employ nearly 21,000 Central Oregonians, or roughly 21.9% of the region’s current total employment.
• More than 100 businesses in advanced manufacturing make their own products here in Central Oregon, as well as provide a critical role in the supply chain for other OEM in aviation/aerospace, brewing & distilling, specialty food processing, and automotive.
• Additive and subtractive machining of metals and plastics, advanced welding and metal fabrication, specialty metals casting, production printing and publishing, as well as specialized machinery and equipment continue to advance locally.
• The largest employers in this industry group include Precision Cast Parts (PCC) Schlosser, Keith Manufacturing and BasX Solutions.






• The production of light aircraft in Central Oregon spans back more than 30 years and over that time, 25 aircraft have moved through the process of conceptual design to flight.
• Composite (carbon fiber) fabrication and innovation aircraft are the region’s specialty offering a cluster of world-class talent and capabilities here.
• Some of the most successful flight training programs in the country are located in the region with both fixed-wing and helicopter flight schools that serve the global industry, including Leading Edge, Hillsboro Aero Academy and Central Oregon Community College.








• Producing everything from titanium implants to cutting edge drug research, our bioscience industry has been experiencing year-over-year double digit employment growth for nearly a decade.
• Quietly, Central Oregon’s bioscience industry has proven capable of attracting world class scientific and technical talent that has made companies here competitive on a global scale.
• Swiss-based pharmaceutical research and manufacturer Lonza is the largest bioscience company in the region, and among the largest in Oregon, with two campuses and additional operations scattered across the region.






• Central Oregon is home to breweries both large and small, with Deschutes Brewery’s production placing it in the top 10 largest craft breweries in the U.S.
• For Oregon, which has 312 craft breweries, nearly one-third of the largest 30 brewers by volume, are located in Central Oregon – testimony to the quality of product produced here.
• The region is also home to a dozen craft cideries and distilleries, two of which, Bendistillery and AVID Cider, are the second largest in the state in their respective sectors.






• After 100+ years and considerable systemic change across the industry, the building products sector is still Central Oregon’s largest traded-sector employer.
• Businesses in this sector compete and win on a global scale, innovating and automating as global leaders in their respective sub-industries, including wood doors and windows, mouldings, cabinetry, furniture, and musical instruments.
• The region’s largest manufacturer and second largest private employer, Brightwood Corporation, is based in Madras, with operations in Redmond, Culver and Prineville. The company has been growing in Central Oregon for over a half century.







• Central Oregon is home to a diverse group of businesses in a variety of subsectors, including rock climbing, water sports, hydration, hiking, backpacking, recreational vehicles, road and mountain biking, outerwear, and software.
• The region is home to the Oregon Outdoor Alliance (OOA) and Oregon’s Office of Outdoor Recreation, both of which are dedicated to connecting and cultivating the industry.
• Bend Outdoor Worx is the country’s first dedicated startup accelerator for the industry and offers investment, exposure and access to vetted resources for outdoor innovators.






#5
GREAT CITIES IN THE U.S. FOR OUTDOOR ADVENTURES
- WASHINGTON POST, 2022
• Professional services are incrasingly being exported out of the tri-county region including engineering, architecture, accounting, HR, recruitment, creative services, advertising, and publishing to name a few
• The creative, marketing and advertising sub-sectors of this industry are particularly strong in Central Oregon with firms being attracted to the region from as far away as Barcelona, Spain.









• Including software companies, electronics manufacturers, alternative energy and data centers, the region has over 130 tech companies employing nearly 3,000 people.
• Five dozen software companies call the region home, more often than not locating their headquarter operations here.
• Prineville is a growing data center hub and is home to Meta’s first and largest data center campus, a 4.5 million square foot complex. Central Oregon offers a unique advantage for data centers due to its available infrastructure, affordable industrial land, multiple telecom carriers, desert climate, and globally competitive tax incentives.






Located on the eastern slopes of the Cascade Range, where vast forests give way to the arid high desert, Central Oregon boasts year-round adventure and a rare mix of city amenities and world-famous outdoor recreation. The region offers the slower speed of a small town with access to toprated healthcare and infrastructure to support continued economic growth.
#10

TOP 100 BEST PLACES TO LIVE IN AMERICA -
#2 MOST FITNESS FRIENDLY PLACE IN THE U.S. -SMARTASSET,
30+ Golf Courses
Miles and Miles of Trails


#10 BEST SMALL CITIES FOR BUSINESS
CHAMBER OF COMMERCE, 2022
M T. BACHELOR
AMONG BEST SKI AREAS IN THE U.S.
BEST PERFORMING SMALL CITIES & #1 FOUR YEARS IN A ROW -MILKEN INSTITUTE, 2022
#4 BEST MOUNTAIN TOWNS IN AMERICA
-THRILLIST, 2021
Flourishing Arts & Culture Scene

31 Breweries & Counting
300 Days of Sunshine


Founded in 1981, EDCO is a non-profit corporation supported by private and public members and stakeholders. Our mission is to create a balanced and diversified economy with a strong base of middle-class jobs in Central Oregon.
To do this, we focus on helping companies do the following:
MOVE. We guide employers outside the region through the relocation process as a resource for regional data, incentives, talent, site selection, and more.
START. We mentor and advise scalable young companies from concept to exit on issues such as access to capital, critical expertise and business strategy.
GROW. We partner with local traded-sector companies to help them grow and expand.
AmeriTitle
BendTel
Cascade Natural Gas
Central Electric Cooperative
Central Oregon Community College
City of Bend
City of La Pine
City of Madras
City of Prineville
City of Redmond
City of Sisters
Combined Communications
Crook County
Deschutes County
First Interstate Bank
Jefferson County
Mid Oregon Credit Union
OSU-Cascades
Pacific Power
PacificSource Health Plans
Schwabe, Williamson & Wyatt
Sensiba San Filippo
St. Charles Health System
U.S. Bank
Velox Systems
Additional information available at EDCOINFO.COM
• Upcoming networking events, luncheons, conferences, and more
• EDCO Info Hub: current comprehensive data for Central Oregon
• Stable of Experts: a network of seasoned professionals with a passion for start-ups and small businesses
• Success stories from regional businesses
• Business news on

